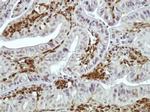
DAB2 Antibody in Immunohistochemistry (IHC)

Search
Invitrogen
DAB2 Polyclonal Antibody
{{$productOrderCtrl.translations['antibody.pdp.commerceCard.promotion.promotions']}}
{{$productOrderCtrl.translations['antibody.pdp.commerceCard.promotion.viewpromo']}}
{{$productOrderCtrl.translations['antibody.pdp.commerceCard.promotion.promocode']}}: {{promo.promoCode}} {{promo.promoTitle}} {{promo.promoDescription}}. {{$productOrderCtrl.translations['antibody.pdp.commerceCard.promotion.learnmore']}}
产品信息
PA5-27130
宿主/亚型
分类
类型
抗原
偶联物
形式
浓度
规格
保存条件
运输条件
RRID
产品详细信息
PA5-27130 targets DAB2 in IHC (P) and WB applications and shows reactivity with Human samples.
The PA5-27130 immunogen is synthetic peptide corresponding to a region within amino acids 708 and 770 of Human DAB2.
靶标信息
DAB2 mRNA is expressed in normal ovarian epithelial cells but is down-regulated or absent from ovarian carcinoma cell lines. The 770-amino acid predicted protein has an overall 83% identity with the mouse p96 protein, a putative mitogen-responsive phosphoprotein; homology is strongest in the amino-terminal end of the protein in a region corresponding to the phosphotyrosine interaction domain. The down-regulation of DAB2 may play an important role in ovarian carcinogenesis. This gene was initially named DOC2 (for Differentially expressed in Ovarian Cancer) and is distinct from the DOC2A and DOC2B genes (for double C2-like domains, alpha and beta).
⚠WARNING: This product can expose you to chemicals including mercury, which is known to the State of California to cause birth defects or other reproductive harm. For more information go to www.P65Warnings.ca.gov.
仅用于科研。不用于诊断过程。未经明确授权不得转售。